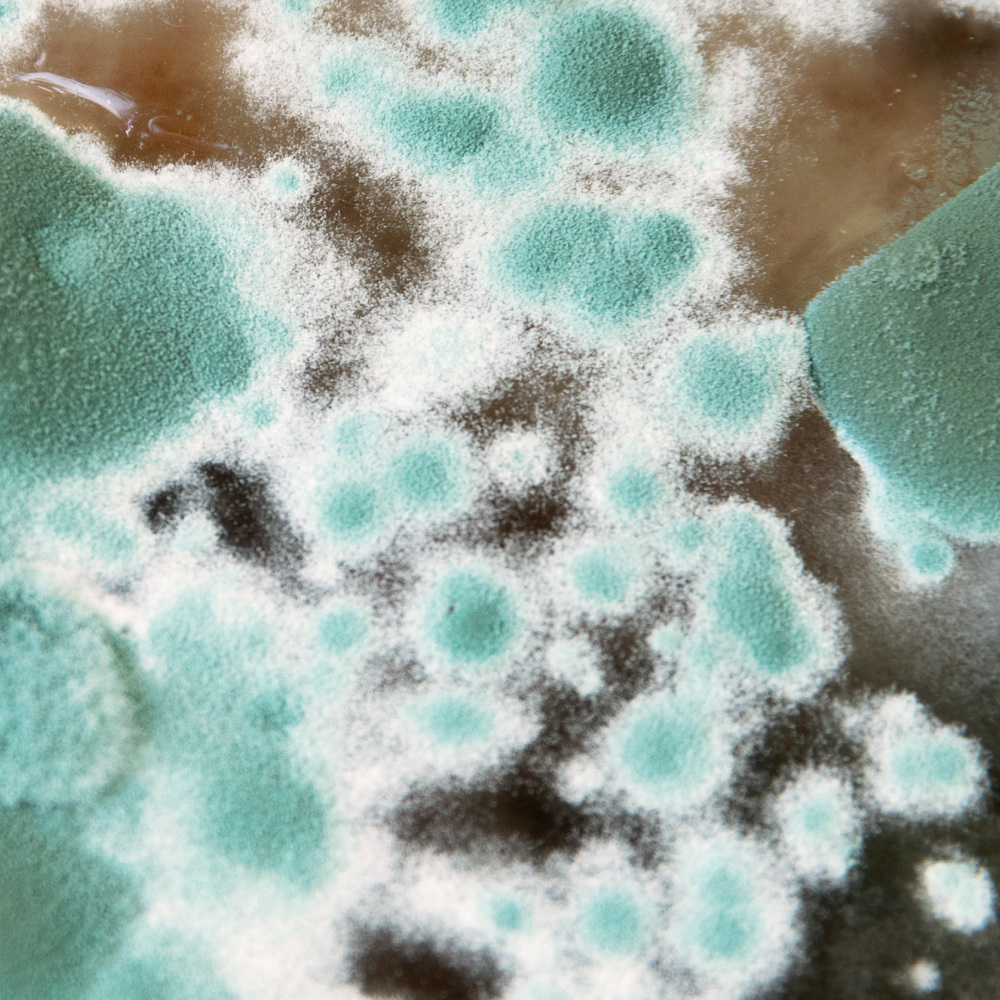
Pollen

IQAir Luftreiniger & Raumklima-Technik
Ihr autorisierter IQAir-Fachhändler in Düsseldorf.
Schweizer HyperHEPA-Qualität für gesundes Raumklima.
IQAir · Made in Switzerland
99,5% Filterleistung
Luftverschmutzung – die gesundheitlichen Folgen
IQAir Systeme zeichnen sich durch zuverlässigste und wirksamste Reinigungsverfahren gegen Luftverunreinigungen in Innenräumen aus.
Pollen, Sporen, Staubmilbenallergene und andere Feinstaubpartikel
können Heuschnupfen, Asthma und andere allergische Reaktionen auslösen.

Flüchtige organische Verbindungen (VOCs)
sind chemische Gase, die von Fahrzeugen, Baumaterialien und Industriewerkstoffen austreten. Sie können krebserregend sein und Schäden an inneren Organen verursachen.

Mikroorganismen
wie Viren, Bakterien und Pilzsporen sind für verschiedene Infektionen wie Tuberkulose, Influenza, Aspergillose, MRSA, und SARS (COVID-19) verantwortlich.

Smog und Ozon
können bereits in geringen Konzentrationen zu Reizungen der Atemwege führen und Asthmaanfälle auslösen. Diese Verunreinigungen werden zwar vorwiegend im Freien erzeugt, können aber über Türen, Fenster und Lüftungsanalgen in Gebäude gelangen.

Haustierallergene
finden sich in der Regel im Speichel und damit auch auf Haar und Haut von Haustieren. Wenn die Allergene eingeatmet werden, können sie zu schweren allergischen Reaktionen führen.

Reinigungsprodukte, Sprays und Lösungsmittel
können die Schleimhäute reizen und Allergien wie Asthma und Heuschnupfen verschlimmern.

Tabakrauch und Feinstaub
enthalten tausende Chemikalien und Partikel, die die Schleimhäute reizen und zu akuten und chronischen Erkrankungen führen können. Selbst ein kurzfristiger Kontakt mit höheren Konzentrationen feiner Partikel kann erheblich zu Herzerkrankungen beitragen.

Farben, Lacke und Klebstoffe
können eine Vielzahl schädlicher Substanzen enthalten. Das einatmen der Dämpfe kann zu Kopfschmerzen, Übelkeit und allergischen Reaktionen führen. Langfristige Exposition kann zu chronischen Erkrankungen führen.
Die gezielte Lösung für Ihre Anforderungen

Unsere Produktbereiche
Von professionellen Luftreinigern über intelligente Raumklima-Sensoren bis zur Trocknungstechnik – entdecken Sie unsere hochwertigen Lösungen.

Luftreiniger
Professionelle IQAir Luftreiniger mit höchsten Wirkungsgraden für saubere Raumluft.

Trocknungstechnik
Professionelle Trocknungsgeräte zur Miete für Gebäudetrocknung.

Ersatzfilter
Original IQAir Ersatzfilter für alle Luftreiniger-Modelle.

Messgeräte
ENERSOR Sammy System zur Raumklimaüberwachung mit WLAN-Sensoren.
Bestseller & Empfehlungen
Unsere meistverkauften und von Experten empfohlenen Produkte für optimale Luftqualität.

IQAir Atem Desk
Persönliche Reinluftzone am Arbeitsplatz
- Persönliche Reinluftzone
- Kompakte Bauweise

IQAir HealthPro 250
Premium Luftreiniger für höchste Ansprüche
- Höchster Wirkungsgrad
- Lange Filterstandzeit

ENERSOR Sammy SystemBasis-Set mit Koffer
WLAN-Raumklimaüberwachung mit automatischer Alarmierung
- WLAN-Sensoren zur Feuchte- und Temperaturmessung
- Automatische Alarmierung bei 80% rel. Feuchte
Warum ENERSOR?
Qualität, Expertise und persönlicher Service – darauf können Sie sich verlassen.
Technische Expertise
Über 10 Jahre Erfahrung als Spezialisten für Raumklima und Gebäudediagnostik. Wir kennen uns aus und beraten Sie kompetent.
Geprüfte Markenprodukte
Keine Billigprodukte: Wir führen ausschließlich professionelle Geräte mit nachgewiesener Qualität und Leistung – insbesondere IQAir aus der Schweiz.
Höchste Filterleistung
IQAir HyperHEPA-Technologie filtert bis zu 99,5% aller Partikel. Bewährt in Krankenhäusern und Reinräumen weltweit.
Zuverlässiger Kundenservice
Persönliche Beratung vor dem Kauf, schneller Support danach. Bei uns stehen Sie im Mittelpunkt – nicht die Produktnummer.
Schweizer IQAir-Qualität
IQAir Luftreiniger werden in der Schweiz entwickelt und hergestellt – nach höchsten Qualitätsstandards und mit modernster Filtertechnologie.
- Keine Ozon-Erzeugung: Kein Einsatz schädlicher Ionisatoren
- Wartungsarm: Langlebige Filter, geringe Betriebskosten
- Bewährt: Eingesetzt in Krankenhäusern und Reinräumen weltweit
IQAir Luftreiniger
Schweizer Qualität